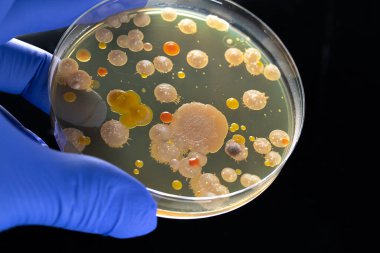
Mavi eldivenli bir bilimsel araştırmacının elinde bakteri ve mantar kirleticileri olan bir petri kabı tutarken. Yeni ilaçların araştırılması için laboratuvar analizi

Arka planda çeşitli petri kaplarıyla çevrili, küf ya da bakteri kültürleriyle dolu bir petri kabını tutan bir el mikrobiyolojik araştırmaları gösteriyor.
İhlal Bildirim Formu
Özel Boyut
(6240 x 4160, jpg)
Geniş Lisanslama
(6240 x 4160, jpg)
* Kurumsal aylık abonelikte çok avantajlı fiyatlar için tıklayın.
* Fiyatlara Kdv dahil değildir.
Örnek Kullanımlar: Web siteleri; reklam afişleri; ekran koruyucuları; sunumlar (PowerPoint, Flash, vs); filmler, videolar veya televizyon reklamları, gazete ve dergilerdeki reklamlar, bastırılmış reklam materyalleri; kitaplar için kapak, iş kartları; el ilanları; posterler; CD/DVD kapakları, etiketler veya ürün paketleri, kırtasiye, dosya, defterler, tükenmez kalem, kalemler, yapıştırmalar; takvimler; fincanlar veya bardaklar; fare altlığı; tişörtler, kıyafet vs. Detaylı Tablo için Tıklayınız!
En Çok Aranan Kelimeler
Sağlık hizmetleriEl.biyolojiLaboratuvarBiyoteknoloji.BakterilerMikrobiyolojiKüfLaboratuvar teknikleriPetri Çanağısteril ortamYaşam BilimleribiyomühendislikLaboratuar teknisyenibilimsel araştırmaKültür ortamıagar tabağılaboratuvar analiziPetri tabağıKlinik Araştırmabilimsel araştırmanınÇevre BilimleriLaboratuvar donatımıbilimsel deneybilimsel bir keşifFen Bilgisi Öğretmenliğiresearch methodsscientific communitylaboratuvar güvenlikakademik araştırmaDeneysel bilimfungal growthLaboratuar örneklerilaboratory settingresearch studyMikrobiyolojik testmicrobiological culturespetri dish collectionBenzer İçerikler